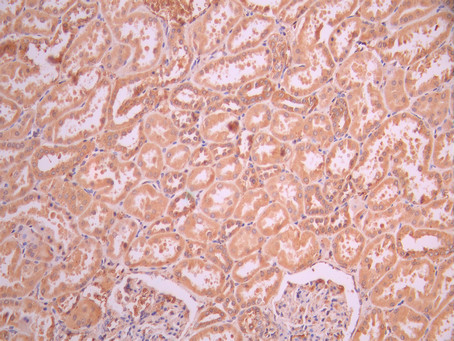

ERLIN2 Recombinant Monoclonal Antibody
-
中文名稱:ERLIN2 Recombinant Monoclonal Antibody
-
貨號:CSB-RA215137A0HU
-
規格:¥1320
-
圖片:
-
Western Blot
, Positive WB detected in:Hela whole cell lysate(30μg), HepG2 whole cell lysate(30μg), A431 whole cell lysate(30μg), HEK293 whole cell lysate(30μg), PC-3 whole cell lysate(30μg), U251 whole cell lysate(30μg), THP-1 whole cell lysate(30μg)
All lanes: Erlin 2 antibody at 1:1000
Secondary
Goat polyclonal to rabbit IgG at 1/40000 dilution
Predicted band size: 38 kDa
Observed band size: 38 kDa
Exposure time:120s -
IHC image of CSB-RA215137A0HU diluted at 1:100 and staining in paraffin-embedded human kidney tissue performed on a Leica BondTM system. After dewaxing and hydration, antigen retrieval was mediated by high pressure in a citrate buffer (pH 6.0). Section was blocked with 10% normal goat serum 30min at RT. Then primary antibody (1% BSA) was incubated at 4°C overnight. The primary is detected by a Goat anti-rabbit polymer IgG labeled by HRP and visualized using 0.05% DAB.
-
IHC image of CSB-RA215137A0HU diluted at 1:100 and staining in paraffin-embedded human liver cancer performed on a Leica BondTM system. After dewaxing and hydration, antigen retrieval was mediated by high pressure in a citrate buffer (pH 6.0). Section was blocked with 10% normal goat serum 30min at RT. Then primary antibody (1% BSA) was incubated at 4°C overnight. The primary is detected by a Goat anti-rabbit polymer IgG labeled by HRP and visualized using 0.05% DAB.
-
Overlay Peak curve showing MCF-7 cells stained with CSB-RA215137A0HU (red line) at 1:100. The cells were fixed in 4% formaldehyde and permeated by 0.2% TritonX-100 for 10min. Then 10% normal goat serum to block non-specific protein-protein interactions followed by the antibody (1ug/1*106cells) for 45min at 4℃. The secondary antibody used was FITC-conjugated goat anti-rabbit IgG (H+L) at 1/200 dilution for 35min at 4℃.Control antibody (green line) was Rabbit IgG (1ug/1*106cells) used under the same conditions. Acquisition of >10, 000 events was performed.
-
-
其他:
產品詳情
-
Uniprot No.:
-
基因名:ERLIN2
-
別名:C8orf2 antibody; Chromosome 8 open reading frame 2 antibody; Endoplasmic reticulum lipid raft associated protein 2 antibody; Endoplasmic reticulum lipid raft-associated protein 2 antibody; ER lipid raft associated 2 antibody; ERLIN 2 antibody; Erlin-2 antibody; ERLIN2 antibody; ERLN2_HUMAN antibody; HGNC:1356 antibody; MGC87072 antibody; NET32 antibody; SPFH 2 antibody; SPFH domain containing protein 2 antibody; SPFH domain family member 2 antibody; SPFH domain-containing protein 2 antibody; SPFH2 antibody; SPG18 antibody; Stomatin prohibitin flotillin HflC/K domain containing protein 2 antibody; Stomatin-prohibitin-flotillin-HflC/K domain-containing protein 2 antibody
-
反應種屬:Human
-
免疫原:A synthesized peptide from human ERLIN2 protein
-
免疫原種屬:Homo sapiens (Human)
-
標記方式:Non-conjugated
-
克隆類型:Monoclonal
-
抗體亞型:Rabbit IgG
-
純化方式:Affinity-chromatography
-
克隆號:24F7
-
濃度:It differs from different batches. Please contact us to confirm it.
-
保存緩沖液:Rabbit IgG in 10mM phosphate buffered saline , pH 7.4, 150mM sodium chloride, 0.05% BSA, 0.02% sodium azide and 50% glycerol.
-
產品提供形式:Liquid
-
應用范圍:ELISA, WB, IHC, FC
-
推薦稀釋比:
Application Recommended Dilution WB 1:500-1:5000 IHC 1:50-1:200 FC 1:50-1:200 -
Protocols:
-
儲存條件:Upon receipt, store at -20°C or -80°C. Avoid repeated freeze.
-
貨期:Basically, we can dispatch the products out in 1-3 working days after receiving your orders. Delivery time maybe differs from different purchasing way or location, please kindly consult your local distributors for specific delivery time.
-
用途:For Research Use Only. Not for use in diagnostic or therapeutic procedures.
相關產品
靶點詳情
-
功能:Component of the ERLIN1/ERLIN2 complex which mediates the endoplasmic reticulum-associated degradation (ERAD) of inositol 1,4,5-trisphosphate receptors (IP3Rs) such as ITPR1. Promotes sterol-accelerated ERAD of HMGCR probably implicating an AMFR/gp78-containing ubiquitin ligase complex. Involved in regulation of cellular cholesterol homeostasis by regulation the SREBP signaling pathway. May promote ER retention of the SCAP-SREBF complex.
-
基因功能參考文獻:
- Novel Mutations in Endoplasmic Reticulum Lipid Raft-associated Protein 2 Gene Cause Pure Hereditary Spastic Paraplegia Type 18 PMID: 27824013
- Erlin-2 and the related erlin-1 were found to negatively regulate cholesterol and fatty acid biosynthesis in cultured cell models when the proteins were depleted by RNAi. The proteins also selectively bound cholesterol. PMID: 24217618
- ERLIN2 was found to be responsible for causing hereditary spastic paraplegia in a Saudi family. PMID: 23085305
- ERLIN2 may confer a selective growth advantage for breast cancer cells by facilitating a cytoprotective response to various cellular stresses associated with oncogenesis. PMID: 22681620
- ERLIN2 loss on cell growth may advance understanding of the mechanism behind motor neuron degeneration in primary lateral sclerosis PMID: 23109145
- a novel brain gamma-secretase associated protein , erlin-2, that resides in detergent resistant membranes and affects amyloid beta-peptide production. PMID: 22771797
- a novel role for ERLIN2 in supporting cancer cell growth by promoting the activation of the key lipogenic regulator SREBP1c and the production of cytosolic lipid droplets. PMID: 22690709
- study describes an extended consanguineous Saudi family in which hereditary spastic paraplegia is linked to SPG18, an autosomal recessive locus, and show it is associated with a nullimorphic deletion of ERLIN2 PMID: 21796390
- The gene encodes endoplasmic reticulum (ER) lipid raft-associated protein 2 that mediates the ER-associated degradation of activated inositol 1,4,5-trisphosphate receptors and other substrates. PMID: 21330303
- SPFH2 as a key endoplasmic reticulum associated degradation pathway component and suggest that it may act as a substrate recognition factor. PMID: 17502376
顯示更多
收起更多
-
相關疾病:Spastic paraplegia 18, autosomal recessive (SPG18)
-
亞細胞定位:Endoplasmic reticulum membrane; Single-pass type II membrane protein. Note=Associated with lipid raft-like domains of the endoplasmic reticulum membrane.
-
蛋白家族:Band 7/mec-2 family
-
組織特異性:Ubiquitous.
-
數據庫鏈接:
Most popular with customers
-
-
YWHAB Recombinant Monoclonal Antibody
Applications: ELISA, WB, IHC, IF, FC
Species Reactivity: Human, Mouse, Rat
-
Phospho-YAP1 (S127) Recombinant Monoclonal Antibody
Applications: ELISA, WB, IHC
Species Reactivity: Human
-
-
-
-
-